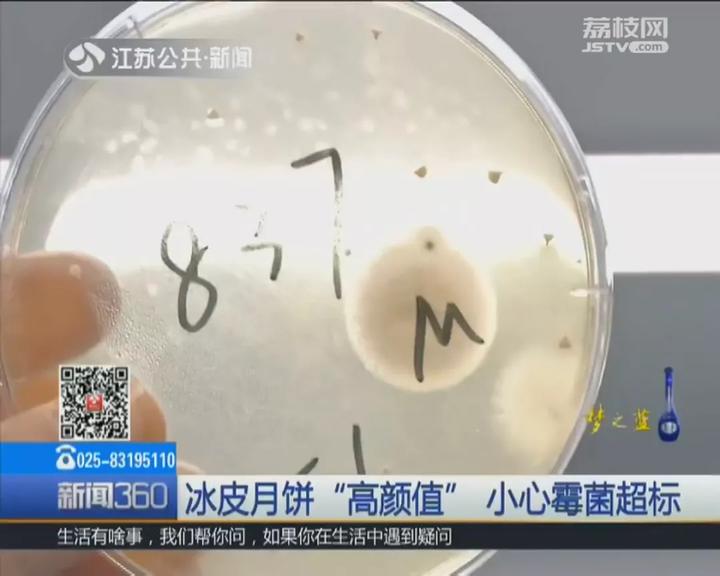
曝光这些月饼不合格别买别吃,月饼不合格最新报道

2018-09-21 00:00 | 中国青年报

近年来,冰皮月饼成为月饼市场上的新宠,但是你知道吗...

霉菌超标:3批次月饼不合格!均为冰皮月饼
“霉菌检出值为2300CFU/g,标准规定不超过150CFU/g...”
近日,江苏省食品药品监管局官网公布“关于538批次食品安全监督抽检信息的通告(2018年第43期)”。
本次通告的中秋专项监督抽检信息共涉及6类食品538批次样品。其中糕点153批次,不合格3批次,均为冰皮月饼!



截图来源:江苏省食品药品监管局官网
3批次不合格月饼分别是:标称为苏州市冠云斋食品厂委托苏州不二家食品有限公司胥口分公司生产的
冰皮月饼(枣蓉味)
冰皮月饼(莲蓉味)
冰皮月饼(红豆沙)

截图来源:江苏公共·新闻频道《新闻360》
霉菌是什么?
江苏省食药监局发布的“说明”显示,霉菌是自然界中常见的真菌,GB7099-2015《食品安全国家标准 糕点、面包》中规定月饼中的霉菌应不超过150CFU/g,GB 19640-2016《食品安全国家标准 冲调谷物制品》中规定纯藕粉中霉菌5次检测结果均不得超过100CFU/g,且至少3次检测结果不超过50CFU/g。
霉菌超标可能的原因有:原料或包装材料受到霉菌污染,产品在生产加工过程中卫生条件控制不到位,生产器具等设备设施清洗消毒不到位或产品储运条件不当等。霉菌污染可使食品腐败变质,破坏食品的色、香、味,降低食品的食用价值。
专家:冰皮月饼更易受微生物污染
据中国新闻网报道,实际上,冰皮月饼的冰皮不是冰,也不是冰淇淋月饼。它的制作原料区别于传统月饼,是用熟糯米粉作皮,莲蓉、豆沙等作馅料,外观呈白色。另外,冰皮月饼需要保存在冷冻箱,售卖时保存在冷藏柜里。
据江苏公共·新闻频道《新闻360》报道,专家指出,冰皮月饼由于制作工艺的特殊性,比传统月饼更容易被微生物污染。
“冰皮比传统的高盐高糖的月饼,更适合微生物生长。”江苏省食品药品监督管理局稽查局副局长周书进介绍,由于冰皮月饼为冷加工食品,缺少高温烘烤的环节,微生物留下比较多。


周书进还建议,谨慎购买冰皮月饼:“冰皮月饼是冷加工工艺,容易在储存、运输中受到污染,买了以后也要尽快食用。”
还有这些注意事项你要知道
一年一度的中秋节又要到了,月饼销售日渐火爆,不仅各大商超、购物网站促销频出,一些“私人定制”“代购海淘”等网红月饼更是受到一些年轻消费者的喜爱和欢迎。

近日,安徽省消保委提醒广大消费者,在月饼消费中要注意以下几点:
“私人订制”要慎选
近年在新零售模式的影响下,一些声称纯手工制做、现做现卖、口味定制、不添加防腐剂的“私房订制”的月饼销售火爆,这些“私房月饼”多出自小作坊,甚至个人,多为“三无”产品,无任何相关资质和许可,质量无法得到保证。
另外,由于这些产品的包装大多是通过网购等渠道批量购买而非定制的,即便生产制作过程能够做到卫生,如果做了就吃没问题。但是要包装销售,仍然会出现二次污染,月饼是高糖分食品,更易受到微生物污染导致食物发生变质。
同时,当前市场上普通快递公司均存在食品与其他物品一起混装运输、递送的问题,也极易产生损伤和污染。
因此建议消费者选购时一定要慎重。
“保健养生” 莫轻信
当前市场上一些月饼为了卖出高价,声称具有保健、养生作用,实际上月饼属于普通节令性食品,即使这些月饼其中含有保健食材,也仅是少量添加,离“保健”作用还差得远。
“无糖月饼”所谓的“无糖”大多是“无蔗糖”并不是一点糖分都没有,用于替代蔗糖的木糖醇本身也有一定热量,其馅料依然以高脂食材为主,因此,如果患有糖尿病消费者在食用仍然要控制量不能多吃。
“月饼当早餐”要不得
经常有消费者把月饼当成了早餐,但是专家指出,月饼可不适宜当早餐。
虽然月饼的能量比较大,但含糖量和油脂较高,空腹吃易引起肠胃不适且营养成分单一不能满足我们早餐对营养的需求。特别是糖尿病、肝胆胰疾病、胃肠病人要切忌。
即使是健康人群,也最好在半空腹状态下将月饼当小点心食用。
另据中国新闻网报道,中秋带大闸蟹、冰皮月饼坐飞机可能过不了安检。
记者向首都机场工作人员了解到,携带活体大闸蟹的旅客,需提前向航空公司咨询能否托运并了解托运要求;携带冰皮月饼的旅客,流体状态的月饼无法携带需办理托运。另外,出境的旅客携带大闸蟹需提前咨询机场卫生检疫部门和对方机场入境部门。

网友热议:


(原标题《这些月饼不合格,竟然有...吓坏网友:吃了几年了》。实习编辑 吴昱燊)